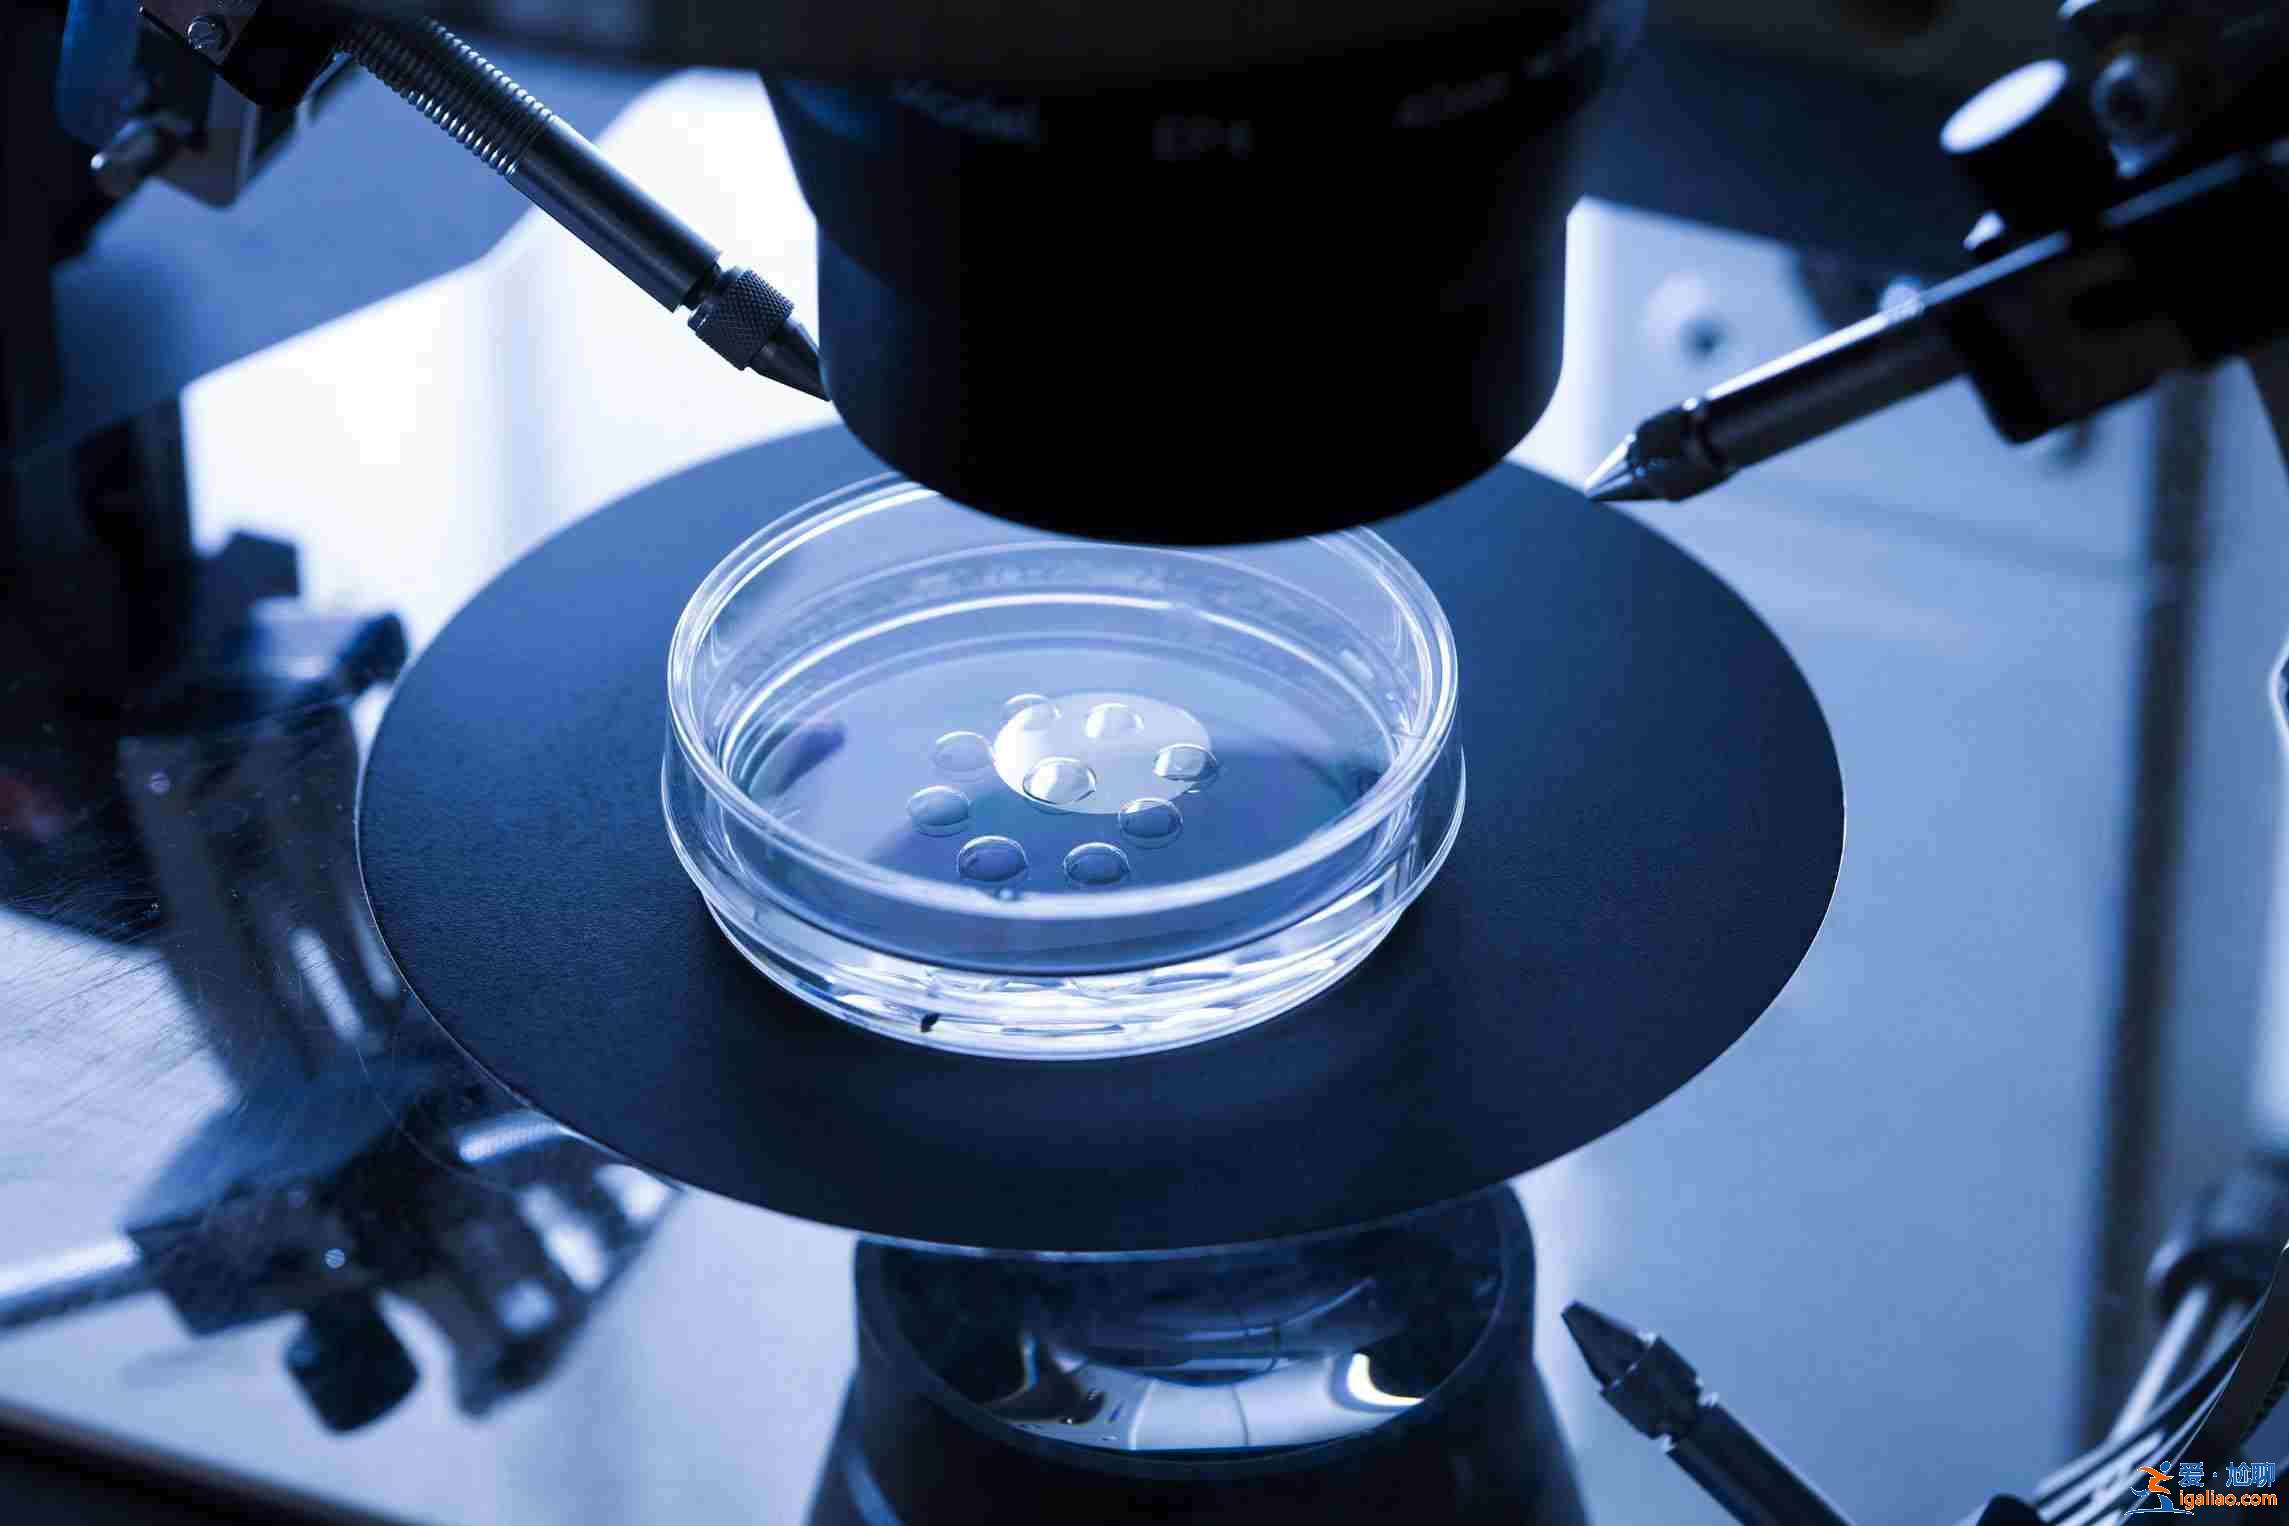

西寧代懷【10天圓夢】?
【aa69助孕中心最良心助孕公司零風險100%包成功,不成功全額退款】,多年國內外操作經驗,成千上萬個家庭的成功案例,專業的生殖醫療團隊,行業超低的價格,助孕首選aa69助孕中心。 【專家團隊】【1w多成功案例】【嚴格挑選】【定制寶寶】【行業領跑】
我們再來一起來看下親們比較關心的幾個問題:
能一次就成功嗎?怎樣提高成功率?
不能,醫療從來不是百分之一百的,即便是正常夫婦備孕,一次就中的幾率也才25%-50%,試管助孕移植成功率也一樣,但是一般檢查通過的話,兩三次移植成功懷孕正常是沒有問題的。
1、年齡因素:供卵滿足了懷孕對卵子的要求,但由于供卵試管嬰兒周期比較長,且治療過程中每個步驟都有可能導致失敗,因此首次供卵試管嬰兒的成功率成為大家關注的重點。
2、子宮因素:優質胚胎也同樣需要良好的子宮環境,好的內分泌條件。子宮肌腺癥、子宮內膜炎、子宮內膜息肉或子宮內膜的其他病變都可能造成胚胎不能著床而影響成功率。
3、心理因素:良好心理狀態是影響試管助孕懷孕成功率關鍵因素。由于心理壓力較重的患者,內分泌會受到影響,進而影響胚胎的順利著床和發育。

詳情請咨詢:文章上方&底部聯系方
我們的優勢:
1、國際品牌:與老牌助孕機構合作,引進全球領先的助孕流程和代母管理體系,高標準給予更高成功率。
2、醫療環境:國內外知名專家,15年以上的臨床經驗,標準化的醫療流程,精湛的醫療技術,單著床率達65%。
3、安全保障:嚴謹的孕期檢查和孕期管理為您的寶寶保駕護航;公司化運作,自購物業辦公,保障資金安全。
4、試管套餐:為每個客戶量身定制服務,并專人一對一責任制服務,盡量讓每一個細節都做到極值,為成功加分!
不孕癥治療的成功率如何?
精液分析對aa69助孕中心試管嬰兒成功率有什么影響
在做aa69助孕中心試管嬰兒前會要求男女夫妻雙方都進行身體檢查,大家知道這個檢查是為了方便醫生評估身體情況,從而確定能不能做試管助孕。其中對于男性來說,有一項特別重要的就是精液分析。
試管<愛尬聊_健康養生>嬰兒價格:
指定性別代懷孕套餐,套餐分為試管嬰兒部分跟代懷孕委托服務部分,一共14萬元起
對于有試管助孕需求,想了解更多捐卵自懷、捐精自懷等一切助孕項目的朋友們。歡迎添加vx免費咨詢:文章底部或右邊聯系欄微信
解答客戶比較關心的幾個問題:
妥運成分是什么?推薦這款產品嗎?
朋友!主要成分是維生素、礦物質和抗氧化劑,我在備孕的時候吃的就是妥 運,我覺得還是有效果的,現在我兒子已經生出來了,健健康康的。
-----------
男性備孕要注意什么,怎樣增加精子的質量?
當然是身體健康問題,男性健康不僅使得Y染色體活躍,生兒子可能性更大,還有助于受孕。所以在備孕開始就給老公買了3瓶康爸爸,就是為了精子質量和數量的改善。
-----------
怎樣增加精子活力,哪些食物有用?
含有維C、維E、鋅、硒等生育酚成分的食物就有作用。不過我當初是直接買了康爸爸,畢竟科學配比的營養品,比食物中的成分更易吸收。
-----------
子宮腺肌瘤和子宮肌瘤的區別?
專家建議:您好!子宮腺肌病是子宮內膜腺體和間質侵入子宮肌層形成彌漫或局限性的病變,與子宮內膜異位癥一樣,屬于婦科常見病和疑難病。子宮腺肌病多發生于30~50歲左右的經產婦,但也可見于年輕未生育的女性,這可能與各種宮腔操作手術增多有一定關系。約15%的患者合并子宮內膜異位癥,約50%合并子宮肌瘤。本病的治療可用異位婦善坊帖緩解, 也可行手術治療,但根治較難,只有患者絕經后子宮腺肌癥 方可逐漸自行緩解。

詳情請咨詢:文章上方&底部聯系方
最后分享一些試管嬰兒常識:
備孕多久能懷上
病情診斷:如果夫妻雙方已經有懷孕的打算,從前期準備到成功懷孕這個時間其實是因人而異的。可以選擇在排卵期同房,增加受孕的幾率。排卵日一般在下次來月經前的14天左右,排卵日的前5天和后4天屬于排卵期,一般在這個時期懷孕的幾率比較高。同時,在備孕前,一定要做孕前咨詢和身體檢查,保證優生優育。如果備孕半年以上還沒有成功懷孕,建議在醫生的指導下進行檢查和對癥治療。平時夫妻雙方都要放松心情,盡量減少自己的心理壓力,注意作息規律和營養均衡,把身體調整到健康的狀態,懷孕自然也是自然而然的事了。
【分期付款】【技術介紹】【頂尖醫療團隊】【成功率高】【10天圓夢】
aa69助孕中心專注于助孕試管嬰兒和第三代試管嬰兒的一體化公司,憑借在輔助生殖技術、先進技術。前端科技,優質醫療資源和助孕師團隊規模各方面的實力,我們為客戶提供豐富高效的助孕解決方案,解決客戶面臨的生育壓力和困境。為你實現圓夢而服務!
以上就是關于《西寧代懷【10天圓夢】》的相關介紹了,受孕是一個非常復雜的過程,積極做好孕前準備是非常重要的,既然選擇了胚胎移植,那么就一定要打起萬分的精神來應對,相信只要積極配合治療、嚴格遵循醫囑,那好孕之路一定會為你敞開。在此祝愿各位好孕哦~~
